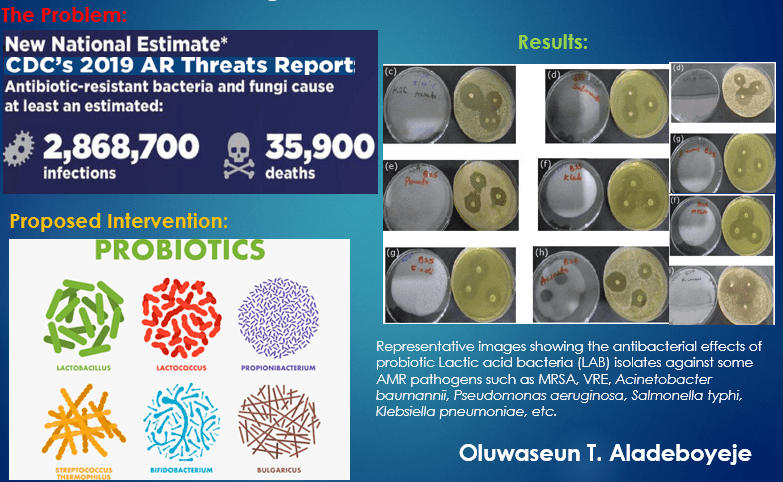

by Oluwaseun Aladeboyeje (ComSciCon Houston)
Originally Published June 25, 2025
Antibiotic‐resistant bacteria are fueling a silent pandemic that now claims millions of lives every year. Our best strategy in overcoming these microbial enemies might be to deploy their kinsmen, i.e., good bacteria (Probiotics) against them. Listen to Seun Aladeboyeje explain more in his mini-podcast below:
Transcript:
Hello everyone, wherever in the world you are listening from. My name is Seun Aladeboyeje. I am a microbiologist and a biomedical science researcher. I will be speaking on the potential of probiotic-derived therapeutics in combating antibiotic resistance.
Now, would you all believe me if I told you that there is a silent killer that kills more people around the world than some of the popular diseases you all are familiar with, like HIV/AIDS, malaria, or any other, for that matter? Are you shocked to hear that? Yes! indeed, there is a silent killer known as antibiotic assistance otherwise called antimicrobial resistance. Antibiotic resistance is the phenomenon whereby microorganisms that cause diseases or germs have developed means to resist the same antibiotics or drugs that once upon a time effectively killed them. And, this has increasingly been a threat to public health over the last few years.
To give you an idea of how enormous this problem is in the United States alone, the United States Center for Disease Control and Prevention, CDC estimated that in 2019, over 2.8 million people got sick with antibiotic-resistant bacteria, and over 35,000 lives were lost to this. On a global scale, the World Health Organization, WHO also in 2019, estimated that nearly 1.3 million deaths were direct result of antibiotic resistance. By 2050, if no serious action is taken, it threatens to be the leading cause of death all around the world.
Therefore, suffice it to say that the world is fast approaching a post-antibiotic era in which new safer, and more sustainable alternatives to antibiotics are imperative in our treatment of infectious diseases. And, one of such alternatives that has been at the forefront of research is probiotics. Simply put, probiotics are beneficial, live microorganisms, or you can just call them “the good bacteria”. So, the term “probiotics” is derived from the Greek term, meaning “for life“. So they support life. There’s overwhelming research evidence showing that these good bacteria can destroy the bad ones that cause harm to our health. Can you imagine that? So, results from my recently published study showed that probiotic lactic acid bacteria, 18 of them that we isolated from some dairy, vegetable, and cereal-based fermented beverages, demonstrated strong antimicrobial effects against some notoriously antibiotic-resistant bacteria, which have been designated by both the CDC and the WHO as an urgent and serious threat to public health.
This data from my study further underscores the enormous health benefits derivable from probiotics, as well as their immense potential for use in the development of new therapeutics in our fight against antibiotic resistance. Now, a top scientist in a publication in 2017, Dr. Gregor Reid, made a commentary and I quote “Until vaccines and other alternatives emerge, it would be foolhardy not to use best practices to bring probiotics into mainstream infectious disease management”. End of quote.
In conclusion, I would like to remind you all that your health is in your hands, not in the hands of any government of your country or the United Nations. therefore, there is something you can start doing today to better your health, to advance your health. We can begin to fortify our Gut health with good bacteria. That is probiotics. So, you can get probiotics-rich beverages – fermented beverages, and strengthen your gut health. Remember, “life starts in the gut” – if you have ever heard of the phrase, it is absolutely true. So, the more you fortify your gut health, the healthier you live and the longer you live. Thank you and God bless.
Oluwaseun Aladeboyeje holds a Bachelor’s degree in Microbiology from the University of Ilorin, Nigeria, a Master’s degree in Microbiology from Istanbul University, Turkey, and a second Master’s in Biology at Texas A&M University, College Station, TX. His research areas of interest and specialization include probiotics, gut microbiome, antibiotic resistance, and gastroenterology. His most recent publication identified the antimicrobial properties of some probiotic lactic acid bacteria (LAB) against broad-spectrum multidrug-resistant bacteria. He received the “Highly Commended” recognition from the Global Undergraduate Awards in Dublin, Ireland in 2014 for emerging among the top 10% most innovative undergraduate research projects. He has reviewed at least 20 manuscripts for reputable international journals focused on probiotics and antibiotic resistance. He is currently pursuing a PhD in Biomedical Sciences at Texas A&M University.

Oluwaseun Aladeboyeje’s professional profile and LinkedIn page can be accessed below:
Texas A&M University: https://vetmed.tamu.edu/gilab/staff/seun-aladeboyeje/
LinkedIn: https://www.linkedin.com/in/oluwaseun-aladeboyeje-b92708a3/